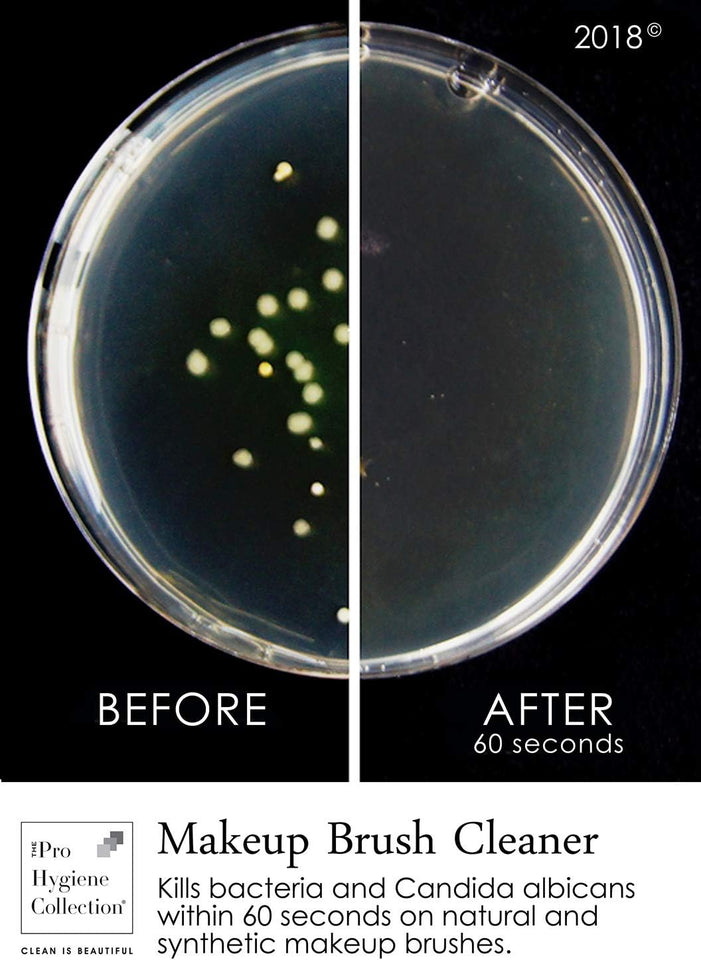
Makeup Brush Cleaner by 240Ml - Cosmetic Tool Cleansers | Buy Online in UK

Makeup Brush Cleaner by 240Ml
Regular price
£0.00
£165.01
ONLY LEFT
- Instant quick dry makeup brush cleaner and sanitizer.
- Antibacterial - cleans and sanitizes natural and synthetic makeup brushes.
- Quick dry, no oily residue, light fragranced.
- Independently tested, kills 99% of bacteria.
- Vegan and cruelty-free. Made in the UK.
Product Description
Quick Dry Makeup Brush Cleaner
Benefits
- Kills 99.9% of bacteria & viruses
- Quick dry formula allows you to clean your brushes within 2 minutes
- Cares for makeup brushes
- Reduces buildup of product
- Improves makeup application
- Helps to prevent clogged pores and improve skin health
How do I use it?
1. Spray the Makeup Brush Cleaner directly onto your makeup brush from 20cm.
2. Wipe your brush on a clean tissue. Wipe the brush in the direction of the hair follicles to help maintain brush integrity.
3. Repeat steps for larger brushes and deeper pigments.
4. Leave brushes to dry for 2 minutes, then use as normal.
What can I use it on?
This specially formulated product is suitable for:
- natural makeup brushes
- synthetic makeup brushes
Why do I need it?
Our quick dry Makeup Brush Cleaner is the perfect solution for cleaning your makeup brushes without having to wait hours for them to dry.
It cleans your brushes from makeup residue, oils and pigmented products.
Not only does it clean but it also sanitises your makeup brushes, reducing the risk of infection.
Not cleaning your makeup brushes can be very damaging and harmful to yourself and your skin. This can lead to very harmful diseases such as dermatitis, acne, pink eye and many more.
people are currently looking at this product
Estimated delivery time 14-30 days
Guaranteed Safe Checkout